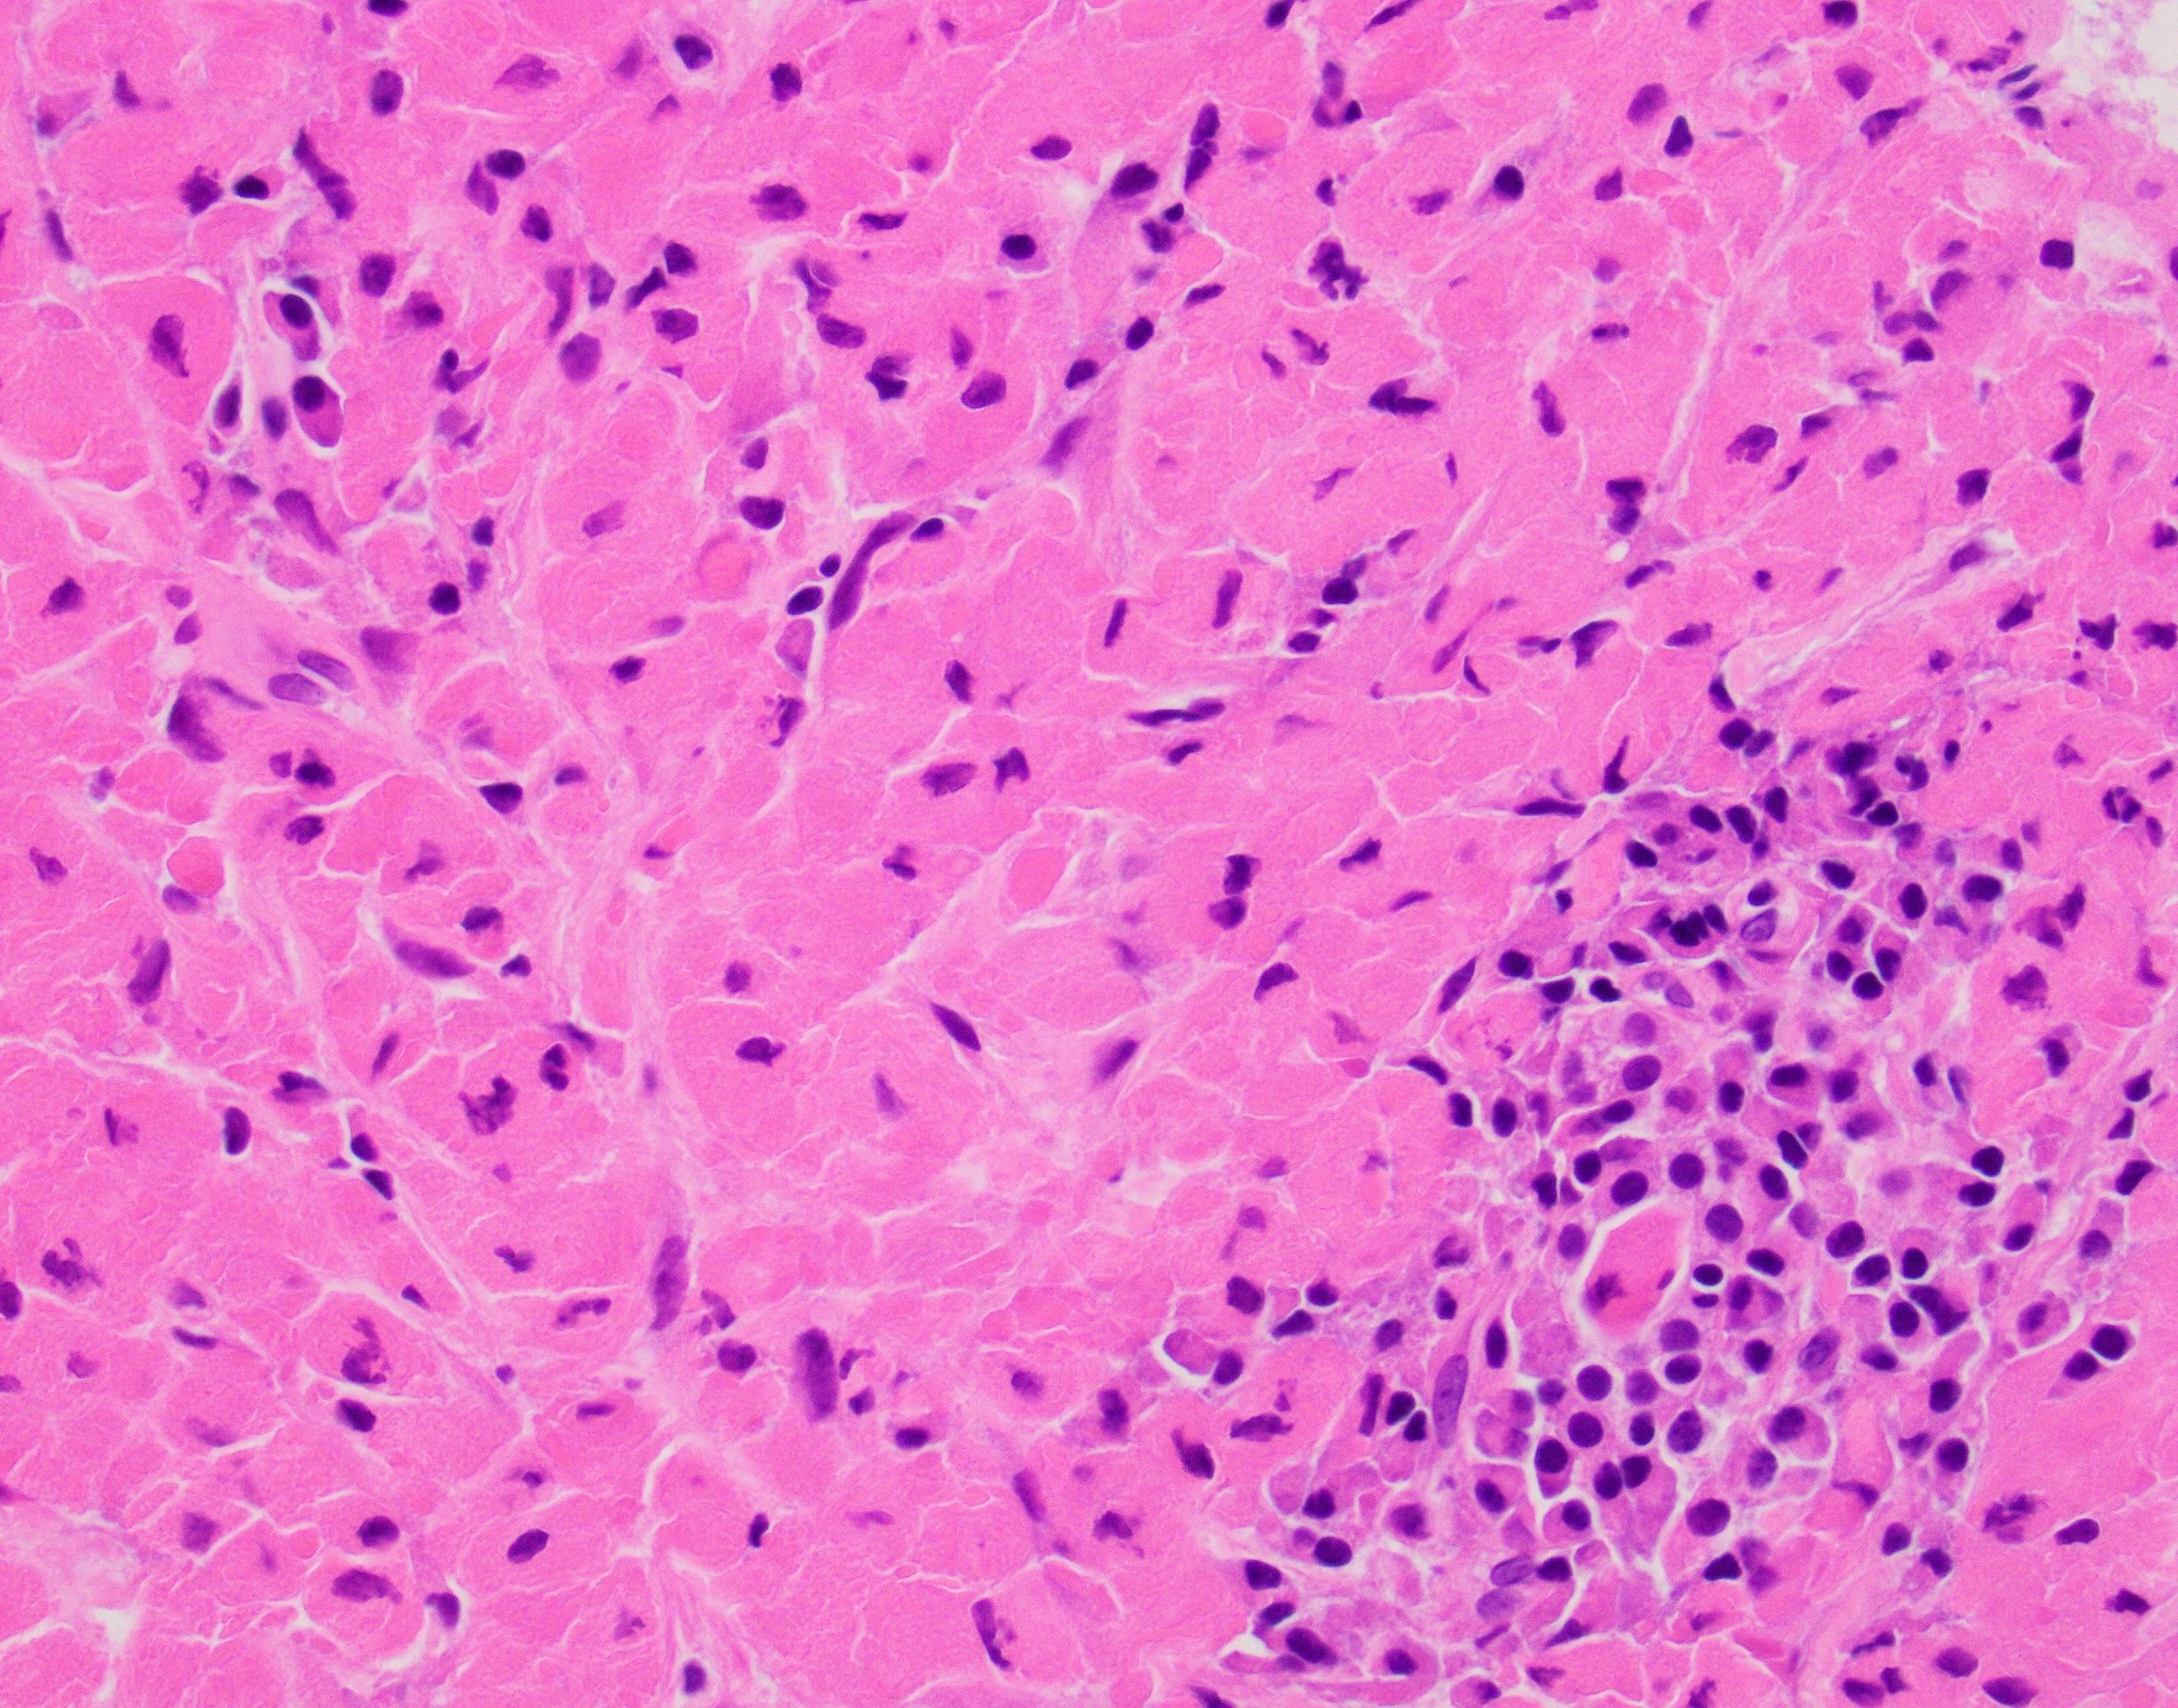
Picture2 small

Case History
A 66-year-old female with right middle lobe lung lesion (A Sox10 immunostain was negative).
What is the diagnosis?
- Granular cell tumor
- Plasmacytoma
- Crystal-storing histiocytosis
- Carcinoid tumor

Answer: "D”, Crystal-storing histiocytosis (Example “A”, Granular cell tumor)
Explantation: H&E sections show a proliferation of histiocytic appearing cells containing brightly eosinophilic crystalloid material that is slightly refringent. In addition there are foci of plasma cells scattered throughout. Immunohistochemical stains for Keratin cocktail, PAX8, Sox10, CD68, CD163 and Kappa/Lambda cocktail were performed with appropriate controls. The cells of interest are strongly immunoreactive for CD68 and CD163 while negative for Keratin cocktail, Sox10 and PAX8. Kappa/Lambda cocktail shows a Kappa light chain restriction in the plasma cells present and the crystalloid material within the histiocytes is also immunoreactive for Kappa light chain.
The overall findings are most consistent with the so-called localized (pleuro) pulmonary crystal-storing histiocytosis a rare disorder that is often related to lymphoproliferative/plasma cell diseases and rarely occurs secondary to long-standing immune-mediated diseases (rheumatoid arthritis) or to chronic use of certain medications (clofazimine).
References
Rossi G, De Rosa N, Cavazza A, Mengoli MC, Della Casa G, Nannini N, Colby TV. Localized pleuropulmonary crystal-storing histiocytosis: 5 cases of a rare histiocytic disorder with variable clinicoradiologic features. Am J Surg Pathol. 2013 Jun;37(6):906-12. doi: 10.1097/PAS.0b013e31827b1618. PMID: 23629440.
Case contributed by: Carlos Prieto-Granada, M.D, Assistant Professor, Anatomic Pathology, Dermatopathology Section Head